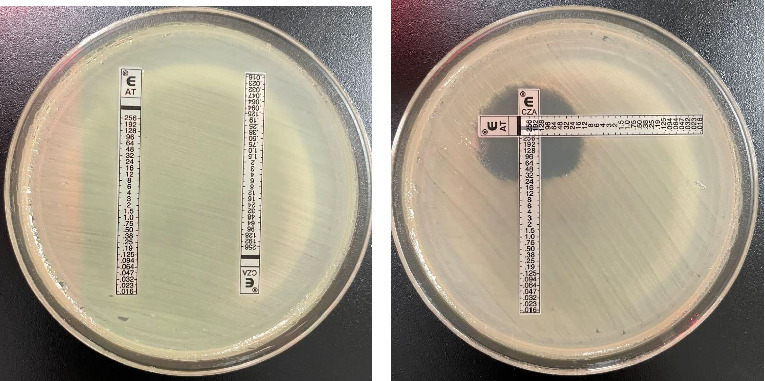

Carbapenem-Resistant Klebsiella pneumoniae Isolated From a Patient in a Midwestern U.S. Hospital With a History of Indian Travel: Therapeutic Strategies and Clinical Outcomes.
IF 0.8
Q4 INFECTIOUS DISEASES
Case Reports in Infectious Diseases
Pub Date : 2025-01-31
eCollection Date: 2025-01-01
DOI:10.1155/crdi/8155592
引用次数: 0
Abstract
Carbapenemases have had increasing prevalence within the United States and worldwide. Here, we present a case of carbapenem-resistant Klebsiella pneumoniae (CRKP) which is unique due to the rarity of multiple mechanisms of resistance within the Klebsiella pneumoniae harboring New Delhi metallo-β-lactamases (NDM), oxacillinase-48 (OXA-48)-like, and cefotaximase (CTX-M) resistance genes, detected in a patient following an international travel. This case demonstrates the need for a multidisciplinary approach to optimize the treatment of multidrug-resistant Gram-negative organisms.

从美国中西部一家医院有印度旅行史的患者中分离出的碳青霉烯耐药性肺炎克雷伯菌:治疗策略和临床结果
碳青霉烯酶在美国和世界范围内的流行率越来越高。在这里,我们提出了一个碳青霉烯耐药肺炎克雷伯菌(CRKP)的病例,由于在肺炎克雷伯菌中含有新德里金属β-内酰胺酶(NDM), oxacillinase-48 (OXA-48)样和头孢噻肟酶(CTX-M)耐药基因的多种耐药机制的罕见性,该病例在国际旅行后的患者中检测到。该病例表明需要多学科方法来优化多重耐药革兰氏阴性菌的治疗。
本文章由计算机程序翻译,如有差异,请以英文原文为准。
求助全文
约1分钟内获得全文
求助全文

 求助内容:
求助内容: 应助结果提醒方式:
应助结果提醒方式:


